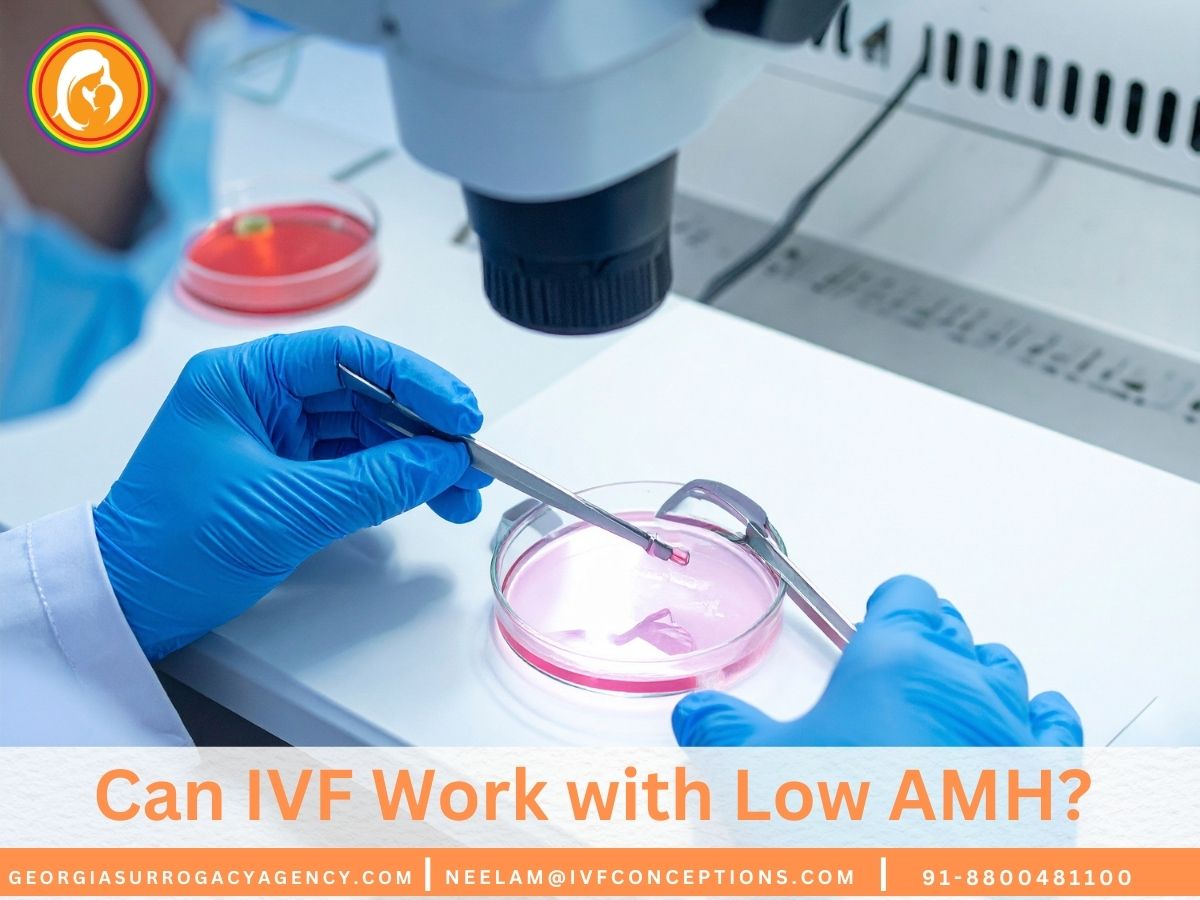
Can IVF Work with Low AMH? Success Rates and Treatment Options

If you’ve been told you have low AMH (Anti-Müllerian Hormone) levels, you may feel overwhelmed or discouraged—especially when considering IVF. But here’s the good news: IVF can still work with low AMH, and thousands of women around the world have successfully conceived despite this challenge.
Low AMH is often associated with diminished ovarian reserve, meaning fewer eggs are available for fertilization. However, it does not reflect egg quality, which is a key factor in successful pregnancy. Advances in fertility science, personalized IVF protocols, and early diagnosis have made parenthood achievable for many women with low AMH.
At Georgia Surrogacy, we specialize in connecting intended parents with cutting-edge fertility clinics that understand the nuanced challenges of low AMH. Our expertise helps patients explore personalized fertility treatment options tailored to their unique reproductive health profiles.
🧪 What Is AMH and Why Does It Matter?
| AMH Level (ng/mL) | Interpretation |
|---|---|
| Above 3.0 | High ovarian reserve |
| 1.0 – 3.0 | Normal ovarian reserve |
| 0.3 – 1.0 | Low ovarian reserve |
| Below 0.3 | Very low ovarian reserve |
Key Takeaways
- Low AMH does not automatically prevent successful IVF outcomes
- Advanced reproductive technologies can help overcome low ovarian reserve
- Personalized treatment protocols exist for patients with low AMH levels
- Comprehensive fertility assessment is crucial for developing effective strategies
- Multiple treatment options are available for individuals with low AMH
📞 Get in Touch for a Free Surrogacy Consultation
📱 +91-8800481100 (WhatsApp | LINE | Viber)
📧 neelam@ivfconceptions.com
🌐 www.georgiasurrogacyagency.com
Understanding AMH and Its Role in Fertility
Egg quality is key to knowing a woman’s fertility. Anti-Müllerian Hormone (AMH) is a major marker in fertility tests. It shows how many eggs a woman has and her chances of getting pregnant.
Doctors use AMH to check how many eggs a woman has and how well she might do with IVF. This hormone gives a peek into a woman’s ability to have children. It helps doctors tailor fertility treatments just for her.
What is Anti-Müllerian Hormone?
AMH is a hormone made by small follicles in the ovaries. It’s a key sign of how many eggs a woman has left. Doctors look at AMH to understand a woman’s chances of getting pregnant.
- Produced by granulosa cells in small ovarian follicles
- Levels stay pretty steady during the menstrual cycle
- Shows how many eggs are left in the ovaries
Normal AMH Levels by Age
AMH levels go down as women get older. This shows a decrease in egg number and quality. Here’s what’s normal by age:
- Age 25-30: 3.0-4.5 ng/mL
- Age 31-35: 2.5-3.5 ng/mL
- Age 36-40: 1.5-2.5 ng/mL
“AMH is like a biological clock for fertility, providing valuable insights into reproductive potential.” – Reproductive Endocrinology Expert
How AMH Affects Fertility
Low AMH levels can mean trouble getting pregnant. Women with low AMH might need special fertility treatments to conceive.
Even with low AMH, getting pregnant isn’t impossible. But it does mean a woman needs a custom fertility plan. Doctors can create treatments that boost a woman’s chances of IVF success, no matter her AMH level.

Can IVF Work with Low AMH?
✅ Yes, it can—but with a tailored approach. Women with low AMH may not respond to traditional IVF protocols as robustly, but success is possible through:
- Personalized stimulation protocols (e.g., micro-dose flare or antagonist protocols)
- High-dose gonadotropins
- Close monitoring to optimize egg retrieval timing
- Adjunct therapies like DHEA, CoQ10, or growth hormone (based on the doctor’s recommendation)
Even with fewer eggs retrieved, the focus shifts to embryo quality, not just quantity.
Can IVF Work with Low AMH
Patients with low AMH levels often worry about their fertility treatment options. Low anti-müllerian hormone levels can make IVF success rates harder. But, recent research gives hope to those facing fertility challenges.
A 2021 study found important information about IVF success with low AMH. Younger patients have similar live birth rates as those with normal AMH levels. This news gives hope to those worried about their AMH levels and fertility.
- Younger patients (under 35) show similar IVF success rates
- Egg quality with low AMH can be optimized through specialized protocols
- Fertility treatment options exist for individuals with low AMH
Age is key in IVF outcomes for patients with low AMH. Women in their late 30s and early 40s face more challenges. Their live birth rates are lower due to lower hormone levels.
Specialized fertility treatments can help. Reproductive endocrinologists suggest personalized plans. These plans consider factors like:
- Overall reproductive health
- Specific IVF protocol selection
- Advanced reproductive technologies
The key is not to lose hope. Many patients with low AMH have successfully conceived. They did so with carefully tailored fertility treatments that meet their needs.
Modern reproductive medicine continues to advance, offering innovative solutions for individuals facing fertility challenges.
IVF Treatment Protocols for Low AMH Patients

Patients with low ovarian reserve face unique challenges in fertility treatment. Understanding specialized IVF protocols can significantly improve success rates for those experiencing poor ovarian response ivf. The right approach can make a substantial difference in achieving pregnancy.
Fertility specialists have developed targeted strategies to address low AMH levels and optimize IVF outcomes. These personalized approaches consider the individual’s specific reproductive challenges.
GnRH Antagonist Protocol Advantages
The GnRH antagonist protocol offers several key benefits for patients with low ovarian reserve and ivf challenges:
- Reduces risk of premature ovulation
- Provides more precise hormonal control
- Allows for more flexible stimulation protocols
Ovarian Stimulation Approaches
Patients with low AMH require carefully designed stimulation strategies. Options for ICSI with low AMH include:
- Mild stimulation protocols
- Natural cycle IVF
- Personalized medication protocols
Medication and Dosing Considerations
Optimizing IVF success rates with low AMH requires precise medication management. Fertility experts typically recommend:
- Higher gonadotropin doses
- Individualized medication protocols
- Close monitoring of ovarian response
A 2013 study revealed that specialized protocols could significantly improve pregnancy rates for patients with low AMH levels.
Each patient’s journey is unique. Consulting with a reproductive specialist can help develop the most effective treatment plan tailored to individual needs and reproductive challenges.
Factors Affecting Low AMH and Treatment Options

Diminished ovarian reserve IVF is a big challenge for those looking to get pregnant. Many things can lower Anti-Müllerian Hormone (AMH) levels. This affects how well a woman can get pregnant.
- Genetic predispositions
- Previous ovarian surgeries
- Autoimmune disorders
- Cancer treatments
- Lifestyle influences
Dealing with low AMH needs a detailed plan. Ovarian stimulation protocols for low AMH are made just for each patient. They aim to improve both the number and quality of eggs.
| Treatment Strategy | Potential Benefits |
|---|---|
| Egg Freezing | Preserves fertility potential |
| Minimal Stimulation IVF | Reduces medication intensity |
| Dietary Interventions | Supports reproductive health |
New methods like DHEA or growth hormone supplements might help. It’s important for patients to talk to fertility experts. This way, they can create a treatment plan that fits their needs.
📊 IVF Success Rates with Low AMH
| Age Group | Average AMH | IVF Success Rate per Cycle |
|---|---|---|
| Under 35 | Low to moderate | 30% – 45% |
| 35–39 | Low | 15% – 30% |
| 40+ | Very low | 5% – 15% |
What Are the Options If IVF Fails with Low AMH?
If multiple IVF attempts with your own eggs are unsuccessful, your doctor may discuss:
Higher success rates (60–70%)
- Suitable for women with very low or undetectable AMH
2. Natural or Minimal Stimulation IVF
Focuses on quality rather than quantity
- Ideal for low responders
3. Embryo Banking
Accumulate embryos over several cycles to increase chances
Expert Tips for IVF with Low AMH
- Get a comprehensive fertility assessment: AMH, AFC (antral follicle count), FSH, and ultrasound.
- Act early: Age and AMH decline together over time.
- Consider supplements: DHEA, CoQ10, omega-3 (consult your fertility doctor).
- Choose a clinic experienced with low AMH cases.
- Discuss realistic expectations and consider backup plans.
Additional Resources to read:
Best countries for Egg donor IVF
Best IVF Doctors in Delhi, India
IVF and Surrogacy Costs Explained
IVF Terminology and IVF Acronym 101
Conclusion
Low AMH is not the end of your fertility journey. With expert care, personalized treatment, and patience, many women have conceived through IVF, even with limited ovarian reserve. Consult a trusted fertility clinic that specializes in low AMH cases and explore all options, from natural IVF to egg donation.
If you’re thinking about IVF, surrogacy, or using an egg donor, talk to a fertility expert. They can guide you through the journey, offering advice and support. Every person’s path is different, and modern medicine is ready to help.
💫 Why Intended Parents Choose Complete Surrogacy for a Safe, Smooth & Successful Surrogacy Journey:
🌍 Access to multiple surrogacy destinations with 15+ years of international experience
🏥 Partnerships with top-tier fertility clinics and agencies, backed by references from past clients
👩🦱 Diverse egg donor options: Asian, Caucasian, African, Oriental, and more
💸 Transparent and affordable pricing—direct payments with no extra agency fees
🔒 No hidden costs—all charges are agreed upon upfront
🤝 Dedicated case manager for personalized support
📲 Fast, honest, and clear communication throughout
📑 Full legal support for visas, documentation, and baby exit processes
🚚 Assistance with frozen sperm/embryo shipment logistics

FAQs for can IVF work with low AMH
What is Anti-Müllerian Hormone (AMH), and why is it important for fertility?
AMH is a hormone made by the ovaries. It shows how many eggs a woman has left. Doctors use it to check how well a woman can get pregnant.
What are considered normal AMH levels by age?
AMH levels change with age. Here’s what’s normal for women in their: • 20s: 2.0-6.8 ng/mL • Early 30s: 1.5-4.0 ng/mL • Late 30s: 1.0-3.0 ng/mL • Early 40s: 0.5-2.0 ng/mL Lower levels might mean fewer eggs, which can affect getting pregnant.
Can IVF still be successful with low AMH levels?
Yes, IVF can work even with low AMH. Low AMH makes it harder, but it’s not impossible. Success depends on age, health, and treatment plans.
What are the best IVF treatment options for patients with low AMH?
There are several options for low AMH patients: • GnRH Antagonist Protocol: Often preferred for low AMH patients • Mild Stimulation IVF: Uses lower medication doses • Natural Cycle IVF: Minimizes medication use • Personalized Medication Protocols: Tailored to individual patient needs • Egg Freezing: Preserving eggs for future use
Are there ways to improve AMH levels or egg quality?
While AMH can’t be greatly increased, you can try: • Dietary changes • Reducing stress • Certain supplements (DHEA, CoQ10) • Lifestyle adjustments • Getting advice from a fertility specialist
What alternative fertility options exist for patients with very low AMH?
For very low AMH, consider: • Donor Eggs: Using eggs from a younger donor • Minimal Stimulation IVF: Fewer medications, lower cost • Surrogacy: Alternative path to parenthood • Embryo Adoption: Using pre-existing embryos
How does age impact IVF success with low AMH?
Age is very important for IVF success with low AMH. Younger women (under 35) have better chances. As you get older, success rates drop, making early planning key.
Should I be discouraged if my AMH levels are low?
No, don’t be discouraged. Low AMH is a challenge, but not a barrier. Many people with low AMH have successful pregnancies. Talking to a reproductive specialist can help find the best path forward.

Highly esteemed, authoritative, and trusted professional with a 14-year of experience in international surrogacy. Advocate for Secure, Legal, and Affordable International Surrogacy.
Neelam Chhagani, MA (Counselling Psychology) and Holistic Infertility and Third-Party Reproduction Consultant.
Member of European Fertility Society, Best Surrogacy Blogger of 2020, with 300 dedicated blogs, and top contributor on Quora for Surrogacy.

Add Your Comment